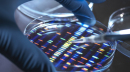

El Dios que no puedes inventar

Cuando sus amigos ateos le preguntaron a WH Auden por qué abandonó su ateísmo por el cristianismo, dijo: “Creo en Jesús porque no cumple ninguno de mis sueños”.
Deja que eso se hunda por un momento.
[Estamos en WhatsApp. Empieza a seguirnos ahora]
Ingrese a la mayoría de las iglesias hoy y le dirán exactamente lo contrario. Como mínimo, el mensaje dado es que Cristo eliminará las dificultades que tienes en la vida y, en algunos casos, la línea dada es que Jesús te quiere rico y en perfecta salud de arriba a abajo.
Suena bastante soñador para mí.
Después de todo, ¿no dijo Cristo: “Venid a mí todos los que estáis trabajados y cargados, y yo os haré descansar… Porque mi yugo es fácil y ligera mi carga” ( Mateo 11:28 , 30 ) . ¿Y no escribió Juan: “Amado, te ruego que seas prosperado en todo y que tengas buena salud” ( 3 Juan 1:2 )?
Sí, lo hicieron. Pero tal vez lo que Jesús quiso decir fue el alivio de la Ley más todo el peso adicional que los líderes religiosos le añadieron, más la libertad del pecado y sus consecuencias. Y tal vez las palabras de Juan reflejen un saludo común del día para que las cosas vayan bien en general, que es lo que significa literalmente el término griego que se usa para “prosperar”.
Siendo ese el caso, volvamos a la declaración de Auden acerca de creer en Jesús porque Él no es un barco de ensueño. ¿De qué trata eso?
Afortunadamente, nos da un poco más de claridad con su declaración de seguimiento: “Él es en todos los aspectos lo contrario de lo que sería si pudiera haberlo hecho a mi propia imagen”. Lo que Auden quiere decir es simplemente esto: Jesús es el Dios que no puedes inventar.
No es un imitador
Hubo un tiempo en que personas históricamente analfabetas afirmaban que Jesús era un invento del mundo antiguo. Por ejemplo, en su libro The Jesus Mysteries , los autores Timothy Freke y Peter Gandy escribieron: “¿Por qué deberíamos considerar las historias de Osiris, Dionisio, Adonis, Atis, Mithras y los otros salvadores paganos misteriosos como fábulas y, sin embargo, encontrarnos esencialmente con la misma historia contada en un contexto judío y cree que es la biografía de un carpintero de Belén?
Bueno, primero comencemos con una declaración de uno de los mejores eruditos del siglo XX sobre el tema, el Dr. Bruce Metzger: “Hoy ningún erudito competente niega la historicidad de Jesús”.
A continuación, es bueno recordar que la inspiración de Freke y Gandy provino de escritores ahora desacreditados, como la controvertida figura de Bruno Bauer (1809-1882), quien presentó una serie de obras ampliamente cuestionadas hace casi 200 años argumentando que Jesús nunca vivió. Su trabajo fue retomado por Albert Kalthoff (1850-1906), quien siguió el escepticismo extremo de Bauer sobre el Jesús histórico y llegó a afirmar que Jesús nunca existió y no fue el fundador del cristianismo. Después de Bauer y Katlhoff vino James Frazer, quien escribió un trabajo titulado "La rama dorada" donde argumentó la teoría de la adoración generalizada de dioses de la fertilidad moribundos y nacientes en varios lugares.
Sin embargo, como siempre sucede cuando las teorías cuestionables se encuentran con una pandilla brutal de hechos, sus afirmaciones han sido completamente rechazadas por la erudición histórica moderna.
Finalmente, el Nuevo Testamento también descarta tales afirmaciones falsas con sus narraciones. La Biblia nos dice que la gente de la época de Jesús no pensaba que Él era el mismo tipo de dioses falsos griegos y romanos.
En cambio, leemos: “'Él [Pablo] parece ser un predicador de deidades extrañas', porque estaba predicando a Jesús y la resurrección. Y lo tomaron y lo llevaron al Areópago, diciendo: '¿Podemos saber cuál es esta nueva enseñanza que estás proclamando? Porque estás trayendo algunas cosas extrañas a nuestros oídos; por eso queremos saber qué significan estas cosas'” ( Hechos 17:18-20 , énfasis mío).
Es por eso que CS Lewis, quien fue profesor de literatura en Oxford y Cambridge, dijo : “He estado leyendo poemas, romances, literatura de visiones, leyendas y mitos toda mi vida. Sé cómo son. Sé que ninguno de ellos es así. De este texto [del Evangelio] sólo hay dos posibles vistas. O esto es un reportaje... o bien, algún escritor desconocido... sin predecesores ni sucesores conocidos, de repente anticipó toda la técnica de la narrativa realista novelística moderna dos mil años antes de que sucediera. El lector que no ve esto simplemente no ha aprendido a leer”.
No, Jesús era algo completamente nuevo. Y esa "novedad" es más de lo que la mayoría de la gente puede soportar, tanto en aquel entonces como en la actualidad.
Un Jesús con bordes duros
Cuando se les preguntó en qué se diferenciaba Jesús de Buda, Confucio y Muhammad Auden respondieron: "Ninguno de los otros despierta todos los lados de mi ser para gritar 'Crucifícalo'".
Lo que Auden está articulando es lo mismo de lo que habla Aristóteles. Cientos de años antes de Cristo, se le preguntó a Aristóteles qué pasaría si se presentara a un hombre perfecto en una sociedad. Respondió diciendo que matarían al hombre porque su belleza y bondad resaltarían dolorosamente las imperfecciones de todos los demás.
Este es el Jesús de la Biblia: uno con bordes duros. Su impecabilidad finalmente provocó un odio explícito o un disgusto silencioso en la gran mayoría de los que lo rodeaban, razón por la cual advirtió: “Bienaventurado el que no se ofende en mí” ( Mateo 11:6 ).
Además, Él no parece tan acogedor como algunos quisieran hacerte creer, al menos no en el sentido liberal extremo. Él nos llama malvados ( Mateo 7:11 ), dice que no somos dignos de Él si no odiamos a todos los demás en comparación ( Lucas 14:26 ), y les dice a los que se oponen a Él que irán al infierno ( Mateo 23:33 ).
No es de extrañar que las Escrituras digan: “Fue menospreciado, y no lo estimamos” ( Is. 53:3 ) y por qué Auden dice que nuestros corazones caídos claman por Su crucifixión.
Entonces, te pregunto: ¿suena esto como un Dios que inventarías? Difícilmente. Como dijo RC Sproul , nadie inventa un Dios como este porque es demasiado traumático: “Porque no hay nada en el universo más aterrador, más amenazante para el sentido de seguridad y bienestar de una persona que la santidad de Dios… Abandonado a nosotros mismos. , ninguno de nosotros inventaría al Dios de la Biblia, el ser que es una amenaza a nuestro sentido de seguridad más primordial y más fundamental que cualquier acto de la naturaleza”.
Es por eso que WH Auden creyó en Jesús y dijo que Él es lo opuesto a lo que sus sueños caídos podrían evocar. En cambio, Él es el Dios que es tan contrario a lo que quisiéramos por nosotros mismos, Él tiene que ser real.